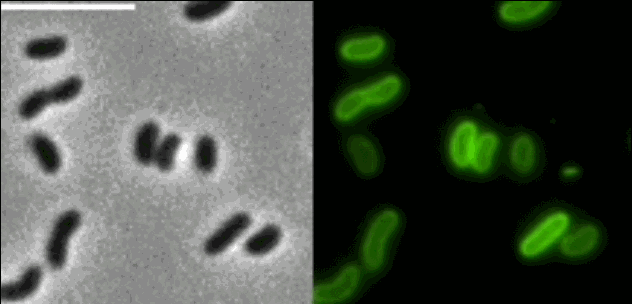
你曾经被哪些自己所学专业的鬼畜知识震惊过

细菌病毒微生物冠状病毒卡通动图gif
2022-04-15 来源:动态图库网

可以抵抗细菌病毒的感染, 提升免疫力,帮助吸收营养成分, 清除有害菌
为指导做好新型冠状病毒感染不同风险人群防护工作,国务院应对新型
mg科普动画—国药集团—猪圆环病毒疫苗—悸动文化
肉眼看不见的细菌,很多同学在科学课上已经知道,真实的冠状病毒有多大
关于新冠病毒,怎样说给孩子听?
关于新冠病毒,怎样说给孩子听?
一剑封喉的神药到底有木有
美国一家专门生产以细菌和其他微生物为原型毛绒玩具的企业"
我们可以阻隔病毒,让他们无计可施
细菌病毒微生物冠状病毒卡通动图gif
新型冠状病毒是如何让我们生病的关于病毒的一切都在这里
你的细胞这么守护你吃掉病毒或与它同归于尽
scratch实战新冠病毒大作战
艾滋病病毒储存库(hiv dna)检测是什么呢?
病毒是一个在生物界中进化的留下了几千万冰冷的尸体有一种病毒也横扫
1毫升海水,百万病毒
诺如病毒的防控
1小.gif
抗击疫情战胜病毒gif
抗击疫情病毒滚开表情包gif
地球最致命的病毒却有可能是人类最后的希望
科技助力共渡难关 3d打印新型冠状病毒模型
你曾经被哪些自己所学专业的鬼畜知识震惊过
呃,草率了!这盏灯……细菌病毒通通灭掉!
【限时抢购】医用75%酒精消毒喷雾,一喷抵御新型病毒!
噬菌体侵染细胞与冠状病毒
美国一家专门生产以细菌和其他微生物为原型毛绒玩具的企业"
聊聊新型冠状病毒
科学医学生物细胞细菌微生物高清视频展示效果 ae片头
孩子也能看懂|新型肺炎防护儿童版动画讲述病毒防护常识!